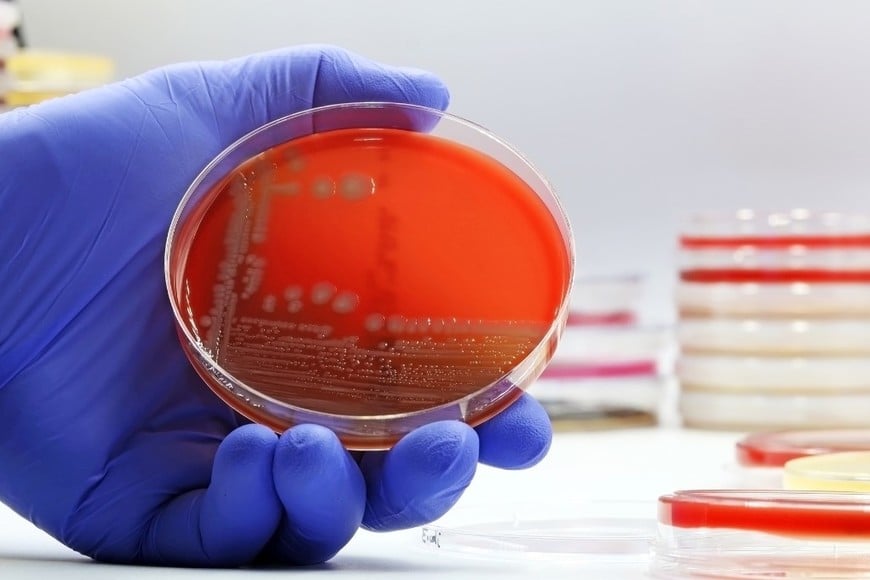
Salta confirmó ocho casos de meningitis y meningoencefalitis.

El Ministerio de Salud Pública de Salta confirmó que, hasta la semana epidemiológica 8, comprendida entre el 22 y el 28 de febrero, se detectaron ocho casos de meningitis y meningoencefalitis en la provincia.

Los pacientes presentaron distintos tipos de infecciones del sistema nervioso central y resaltaron la importancia de consultar de inmediato ante síntomas como fiebre alta, dolor de cabeza intenso y rigidez de cuello.

El Ministerio de Salud Pública de Salta confirmó que, hasta la semana epidemiológica 8, comprendida entre el 22 y el 28 de febrero, se detectaron ocho casos de meningitis y meningoencefalitis en la provincia.
Estas infecciones afectan distintos tipos de patologías del sistema nervioso central, lo que obliga a mantener una vigilancia epidemiológica activa y a prestar especial atención a la aparición de síntomas.

Según el informe oficial, los ocho casos confirmados incluyen tres de meningoencefalitis viral, dos de meningitis tuberculosa, uno de encefalitis por herpes simple, uno de meningitis fúngica y uno de meningoencefalitis bacteriana.
El Ministerio aclaró que, aunque los cuadros presentan distintos orígenes y grados de gravedad, es fundamental no minimizar los síntomas compatibles y consultar de inmediato ante cualquier señal de alerta.
La meningitis es una enfermedad que consiste en la inflamación de las meninges, las membranas que recubren el cerebro y la médula espinal. En algunos casos, la inflamación compromete también el encéfalo, cuadro que se denomina meningoencefalitis.
Estas afecciones pueden tener un origen infeccioso o no infeccioso, siendo las causas virales y bacterianas las más frecuentes y las de mayor relevancia para la salud pública debido a su potencial para producir brotes.

El Ministerio de Salud remarcó que estas enfermedades generan preocupación porque pueden evolucionar rápidamente y dejar secuelas si no se detectan a tiempo. Por ello, insistieron en que la población debe mantenerse atenta y acudir de inmediato al médico ante fiebre alta, dolor intenso de cabeza, rigidez en el cuello, vómitos o alteraciones del estado general.